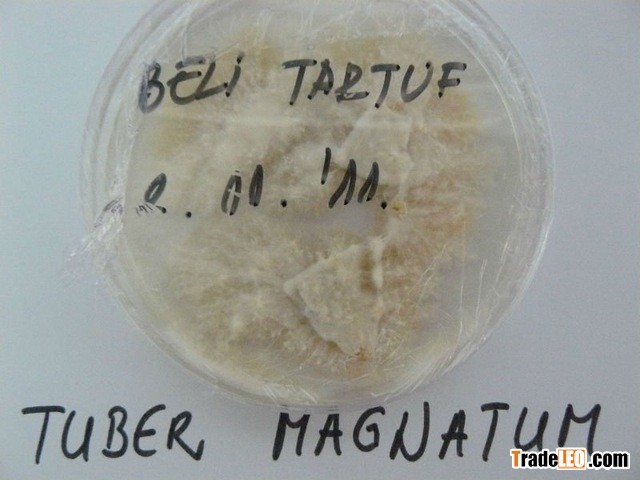

Brand:MICELIUM FOR WHITE/BLACK TRUFFLES
Send Inquiry
| Product Type: | Truffles |
|---|---|
| Color: | white/yellow and ligh brown |
| Shape: | micelium |
| Source: | Wild |
| Processing Type: | micelium |
| Part: | micelium |
| Place of Origin: | Serbia |
| Brand Name: | MICELIUM FOR WHITE/BLACK TRUFFLES |
| Style: | micelium |